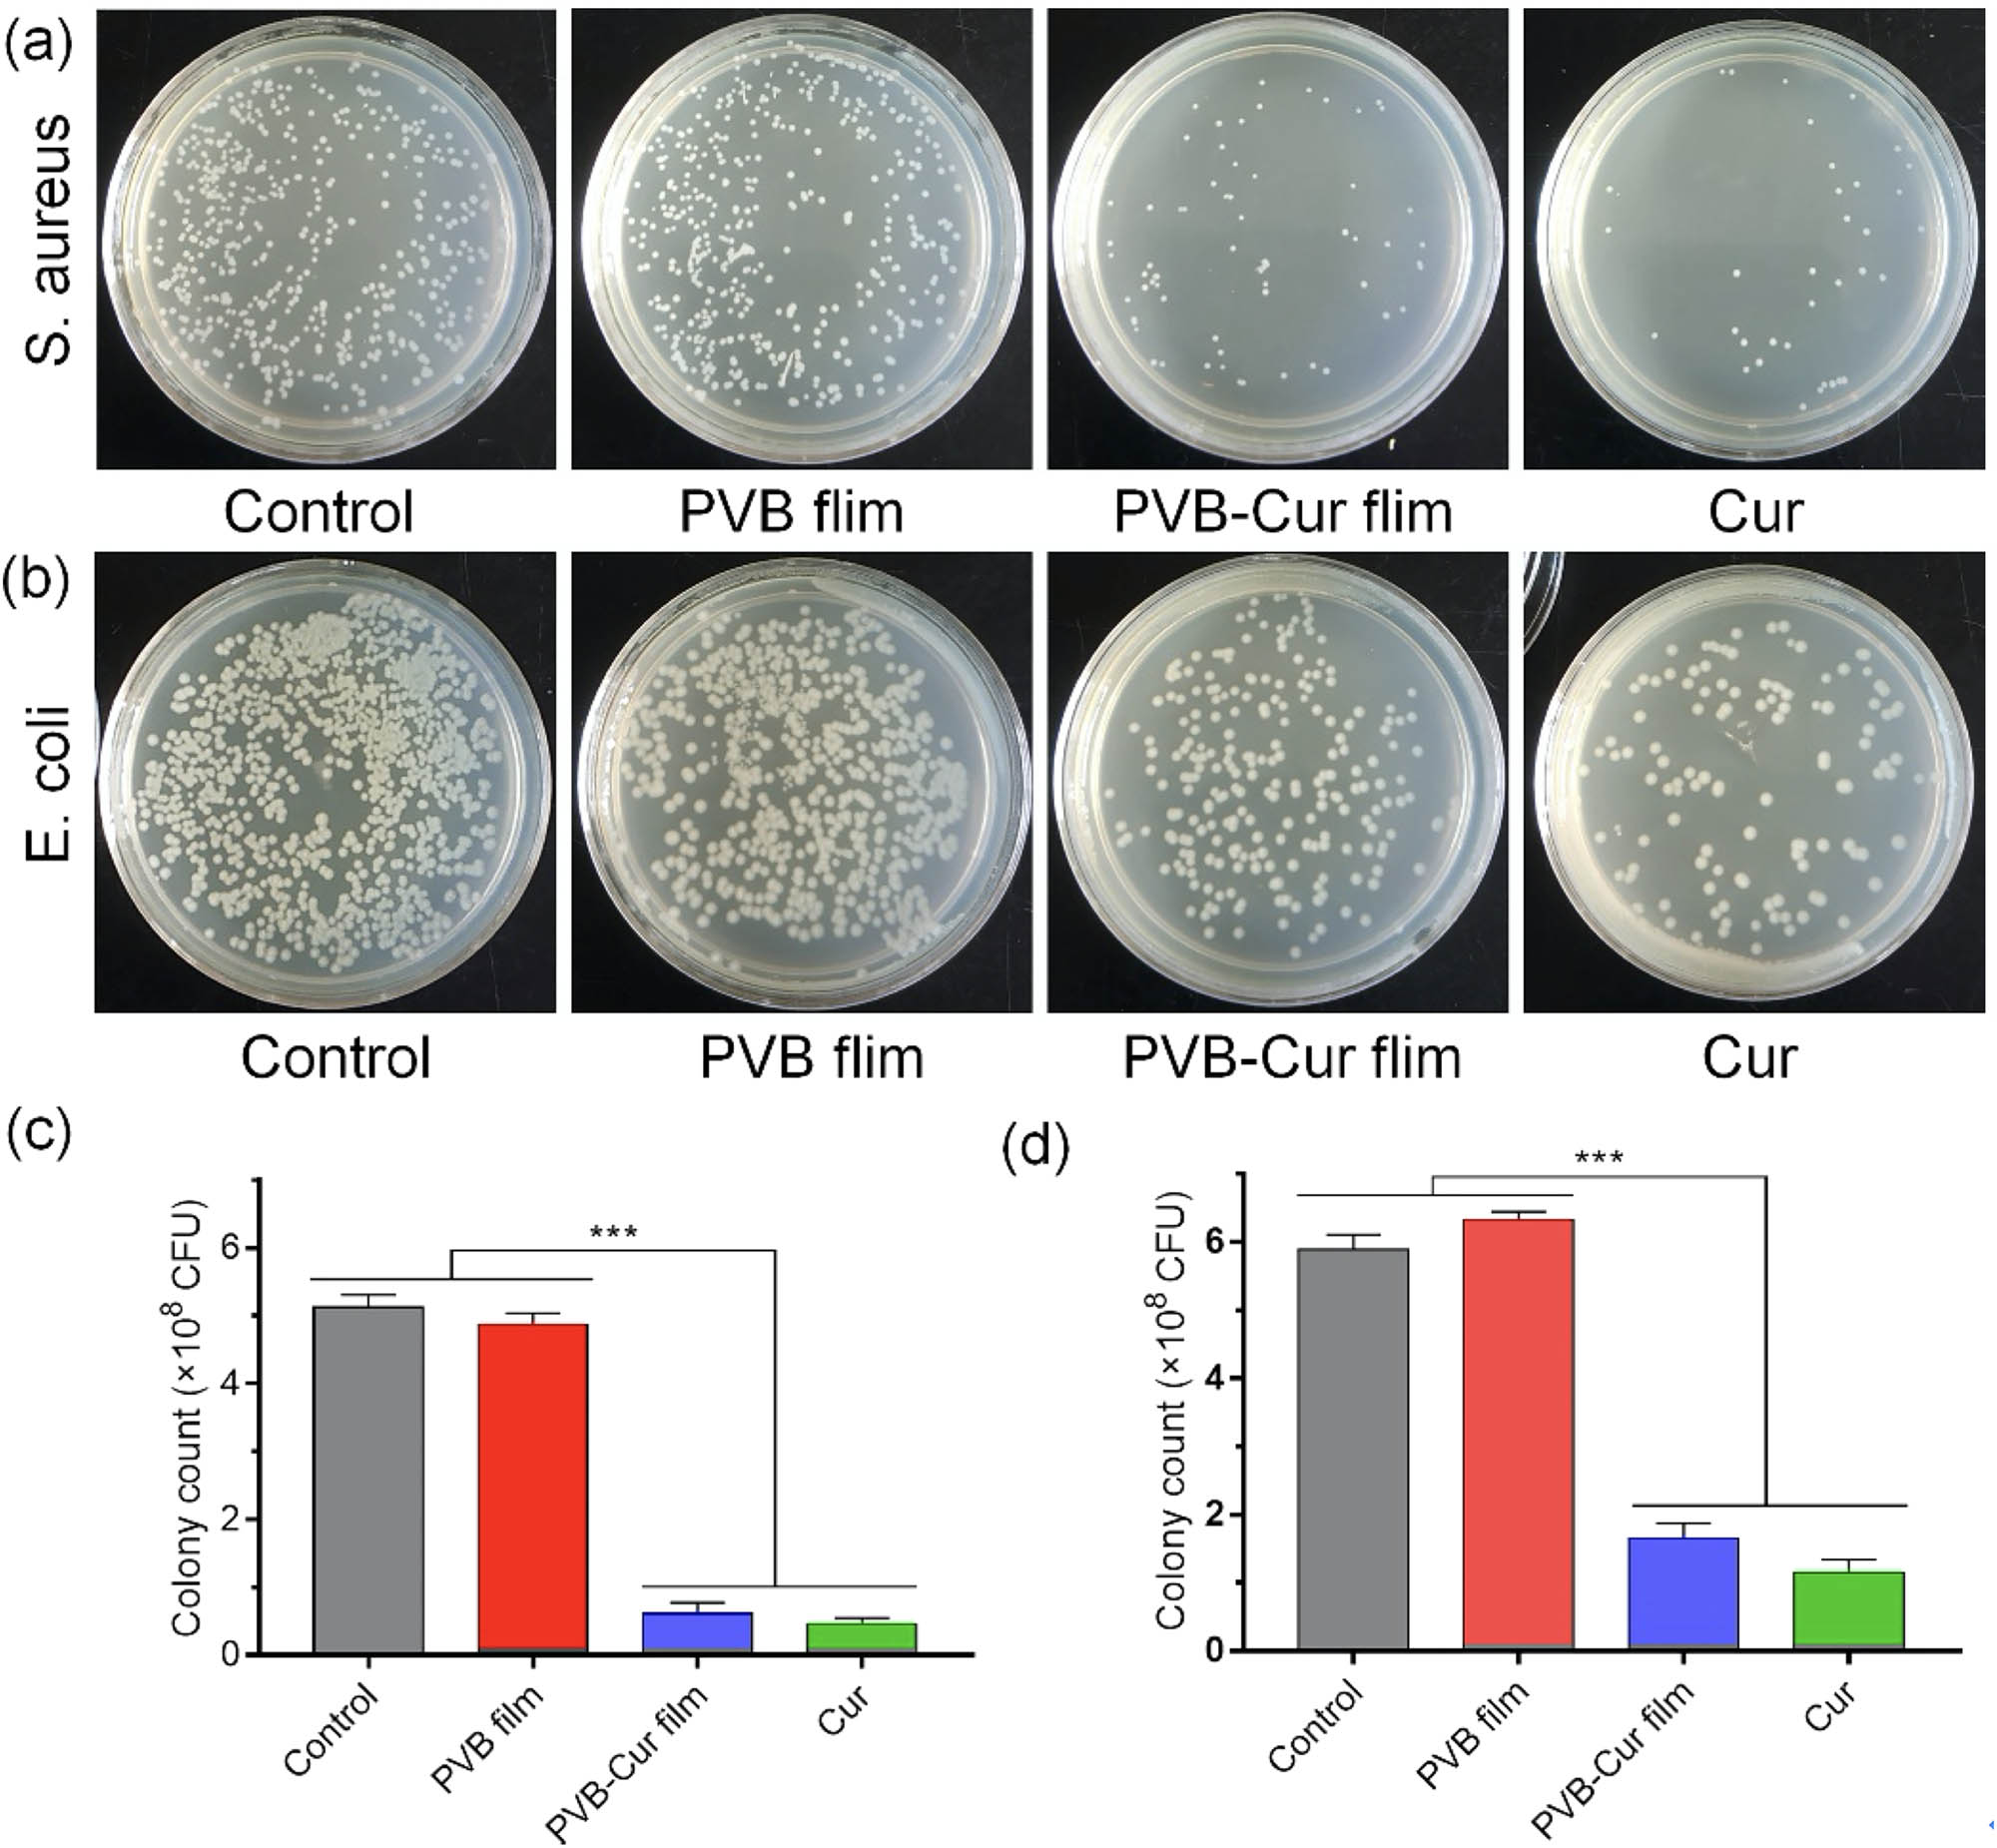
Figure 7 Antibacterial assays of S. aureus and E. coli. CFU photographs of S. aureus (a) and quantitative results (c). CFU photographs of E. coli. (b) and quantitative results (d).

Abstract
Antibacterial materials have found widespread interest in different fields nowadays. In this study, curcumin (Cur) was incorporated into the polyvinyl butyral (PVB) matrix by dissolving in ethanol for improving the functional properties of a pure PVB film. We found that Cur was uniformly dispersed in the PVB matrix, which showed good compatibility. Moreover, the incorporation of Cur could also improve thermal stability, hydrophilicity, and mechanical property. The UV-vis spectra of the PVB–Cur film demonstrated that the film could block ultraviolet radiation. Subsequently, the antibacterial activity of the PVB–Cur film was measured by the colony-counting method against S. aureus and E. coli. The results showed that the PVB–Cur film exhibited good antibacterial activity. Therefore, the PVB–Cur film was considered as a promising material for food and medical packaging applications.
1 Introduction
In recent years, various films, especially the antimicrobial films, have been rapidly developed. Usually, antimicrobial materials such as silver nanoparticles (1), metal oxides (ZnO, CuO, TiO2) (2), organic acids (benzoic acid, sorbates) (3), enzymes (lysozyme, glucose oxidase) (4), natural active compounds (essential oil, biopolymer, pomegranate-rind extract, and curcumin (Cur)) (5,6,7), antibiotics, triclosan, and other functional ingredients were incorporated into polymers (natural or synthetic) to fabricate antimicrobial films (8,9). Furthermore, some researchers prepared multifunctional composite materials with antibacterial activity and antioxidant activity (10,11).
Cur [1,7-bis(4-hydroxy-3-methoxyphenyl)-1,6-hepadiene-3,5-dione] is a kind of polyphenolic phytoconstituent found in the rhizomes of Curcuma longa (turmeric) with antibacterial, anti-inflammatory, anticancer, and antioxidant activities (12,13,14). Turmeric has been used as a spice and traditional natural herbal medicine for thousands of years (15,16). The Cur extracted from turmeric has reactive oxygen species scavenging ability to improve the wound healing process due to a large number of phenolic hydroxyl groups in the molecule chain (17). Clinical trials have shown that Cur was safe, even when applied to humans at high doses (12 g/day) (18).
In previous work, Liu et al. prepared Cur–chitosan (Cur–CH) blend films by the solution casting technique. The resulting blend films showed excellent tensile strength and antibacterial activity (19). Luo et al. prepared cellulose/Cur composite films using ionic liquid (1-allyl-3-methylimidazolium chloride (AmimCl)) as a solvent. The composite films containing Cur exhibited good mechanical properties, thermal stability and antibacterial activity, which could be applied in food packaging and medical fields (20). Moreover, Govindaraj et al. fabricated C. longa oil-loaded polyacrylonitrile (PAN) films by the facile solvent casting technique. Incorporation of C. longa oil into the PAN matrix increased the hydrophilicity of the films (21). Besides, Li et al. developed a methoxy poly(ethylene glycol)-graft-chitosan film loaded with Cur nanoformulation (Cur–MPEG–chitosan film). The in vivo wound healing test showed that the Cur–MPEG–chitosan film was effective in wound healing (22).
Polyvinyl butyral (PVB) is synthesized by the acetalization of polyvinyl alcohol (PVA) and butyraldehyde under acidic conditions. PVA is a polymer prepared from the polyvinyl acetate precursor; thus, a small portion of vinyl acetate units remain in the PVA (23). Therefore, PVB can be regarded as a ternary random polymer mainly composed of vinyl butyral and vinyl alcohol units and containing a small number of vinyl acetate units. PVB can be made into films with excellent mechanical property, optical clarity, biocompatibility, nontoxicity, and adhesive property (24,25).
In this investigation, we incorporated Cur into the PVB matrix using ethanol as solvent to fabricate Cur-loaded films (26,27,28,29,30,31). The films were characterized by Fourier transform infrared (FTIR) spectroscopy and UV-vis spectroscopy. The results indicated that the Cur was uniformly dispersed in the PVB matrix. In addition, the resultant PVB–Cur film exhibited thermal stability, high hydrophilicity, excellent mechanical strength, UV resistance, and antibacterial activity, which implied the potential applications in food packaging and medical fields.
2 Experimental
2.1 Materials
PVB (MW 40,000–70,000) and Cur (AR) were bought from Shanghai Macklin Biochemical Co., Ltd, China. Ethanol (AR) and sodium chloride (NaCl) (AR) were supplied by Beijing Chemical Works, China. Yeast extract (FMB Grade) was obtained from Shanghai Sangon Biotech Co., Ltd, China. Peptone (BR) was purchased from Beijing Aobox Biotechnology Co., Ltd, China. Agar powder (AR) was bought from Tianjin Guangfu Fine Chemical Research Institute, China. The species of bacteria were Staphylococcus aureus (S. aureus) (ATCC25923) and Escherichia coli (E. coli) (ATCC-25922), respectively.
2.2 Preparation of Cur-loaded PVB film
PVB films with Cur were prepared by a solution casting technique. Firstly, the PVB solution (6% w/v) was prepared by dissolving PVB in ethanol and the mixture was stirred using a magnetic stirrer hot plate (IKA, RT 15 S025, Germany) at 30°C with a rotor speed of 400 rpm. The transparent and homogeneous solution was obtained after being mixed for 90 min. Cur was subsequently added to the solution and continuously stirred for 30 min. The added content of Cur was 5% of the weight of PVB, which was determined through preexperiments of tensile strength and antibacterial activity. The mixtures were ultrasonically treated at an ultrasonic power of 200 W and a frequency of 40 kHz for 10 min. The stable and homogeneous solution was cast onto the polyfluortetraethylene plate and then dried at 37°C to obtain films. The prepared composite films were defined as PVB–Cur films (Figure 1). For comparison, the pure PVB films were prepared by the same method.

Schematic diagram of Cur-loaded PVB films.
2.3 FTIR analysis
The FTIR spectra of films were recorded on an iS50 FTIR spectrometer (ThermoFisher Nicolet, USA) with attenuated total reflection mode at room temperature, and the spectra of the films were scanned in the range of 500–4,000 cm−1 with a resolution of 4 cm−1.
2.4 Optical property
The ultraviolet and visible light barrier properties of PVB and PVB–Cur films were measured by using an ultraviolet-visible spectrophotometer (PerkinElmer, Lambda 25, USA). The film samples were cut into rectangular pieces (4 cm in length and 1 cm in width) and placed into the cuvette of spectrophotometer. The analyses were performed in triplicate. The transmittance of the film was measured in the wavelength range of 200–800 nm. Measurements were performed using air as a reference. The value of transparency is calculated, based on the transmittance of the film at 600 nm:
where T600 is the percentage transmittance (%) at 600 nm and d is the film thickness (mm).
2.5 Thermogravimetric analysis (TGA)
The thermal stability and degradation characteristics of the films were carried out on a thermogravimetric analyzer (METTLER TOLEDO, TGA 2, Switzerland). The sample weights for the test were 2–4 mg. The samples were heated up from 50°C to 600°C at a heating rate of 10°C/min under nitrogen atmosphere with a nominal gas flow rate of 50 mL/min.
2.6 Film thickness
The thickness of the films was determined by using a spiral micrometer (Ningbo Shiji Bosi Tools Co., Ltd, China). Six thickness values were randomly measured at different locations on each film and their average thickness values were calculated.
2.7 Mechanical property
The mechanical properties of PVB and PVB–Cur films were determined by using a tensile tester (SHIMADZU, AGS-X, Japan) with a 100 N load cell at a tensile rate of 5 mm/min. The initial grip separation was set at 35 mm and all samples were cut into strips (size of 5 mm width × 60 mm height). All the determinations were performed at room temperature of 25°C and were made in triplicate. The values of tensile strength and elongation at break were directly determined from the stress–strain curves (32).
2.8 Contact angle measurement
The water contact angle of the films was determined using a contact angle measurement instrument (HARKE-SPCA, Beijing, China). The samples (20 mm × 60 mm) were fixed to the glass substrate and their wettability was evaluated by a sessile drop method. A droplet (10 μL) of deionized water was placed on the film surface using a micro-syringe. The side-view images of the water droplets were recorded. The contact angles were measured. All measurements were performed at room temperature. The contact angle was measured at five random sites and then the average angle was taken.
2.9 Antibacterial activity assay
The antibacterial activity of the films was evaluated by the colony-counting method. Colony forming unit (CFU) assay was performed on two bacteria of S. aureus (ATCC25923) and E. coli (ATCC25922) isolates to determine the antimicrobial activity of the PVB–Cur film. A suspension of 108 bacteria was incubated with 1.0 mL of Luria–Bertani (LB) liquid culture medium containing PVB–Cur film (5.0 mg mL−1), and compared to the untreated control, PVB film (5.0 mg mL−1), free Cur (5.0 mg mL−1, turbid liquid) groups. Tubes were incubated at 37°C for 4 h using a tube rotator to ensure a uniform distribution. After incubation, suspensions were serially diluted in phosphate buffer solution, plated onto tryptic soy agar, and incubated for 24 h at 37°C under aerobic conditions. Individual colonies were counted and the number of CFUs was tabulated.
3 Results and discussion
3.1 Chemical structure
The FTIR spectra of Cur (powders), PVB and PVB–Cur films are presented in Figure 2. In the spectrum of Cur, the peak at 3,501 cm−1 corresponded to the phenolic –OH stretching vibration. The absorption peak at 1,626 cm−1 was attributed to C–O stretching. The peaks at 1,601 and 1,505 cm−1 corresponded to C–C stretching in the benzene ring (33). The bands at 1,274 cm−1 corresponded to C–O of enol. Additionally, the bands in the region of 960–806 cm−1 belonged to C–H out-of-plane bending and aromatic stretching. PVB showed an absorption band at 3,443 cm−1 due to the –OH stretching, corresponding to the hydrophilic hydroxyl group in PVB. The peaks at 2,955 and 2,870 cm−1 were attributed to the asymmetric and symmetric –CH2 stretching, respectively. The peak presented at 1,737 cm−1 was attributed to the carbonyl group double bond (C–O). The peak at 811 cm−1 was related to the presence of acetal groups. The out-of-plane bending hydrogen bond to the carbonyl group was observed at 1,053 cm−1 (34). The peak at 1,130 cm−1 was related to the vibration of C–O–C, and the peak of 1,432 cm−1 was due to –CH2 bending. The characteristic peaks of Cur and PVB were presented in the spectrum of PVB–Cur films. It should be noted that in the spectrum of PVB–Cur film, the –OH stretching vibration of PVB showed a low-shift from 3,443 to 3,409 cm−1. In addition, the C–O stretching of Cur shifted from 1,626 to 1,622 cm−1; meanwhile, the C–C stretching in benzene ring at 1,601 and 1,505 cm−1 was shifted to 1,586 and 1,512 cm−1, respectively. These results demonstrated that the hydrogen bonding between PVB and Cur was generated in PVB–Cur films. In brief, PVB and Cur had been compounded together excellently.

FTIR spectra of Cur, PVB, and PVB–Cur film.
3.2 UV-vis analysis
Figure 3a shows the light transmittance of PVB and PVB–Cur films. The transmittance of the PVB film reduced at 600–200 nm. Moreover, the transmittance value of the PVB–Cur film almost reduced to 0% in the wavelength range of less than 500 nm. As we have known, Cur belongs to the class of phenolic compounds which is rich in unsaturated bonds, thus facilitating the absorption of ultraviolet radiation. Therefore, PVB–Cur film had superior UV-blocking properties than a PVB film. This film might effectively reduce the oxidative deterioration of food caused by light induction (35). Moreover, since UV light has a significant effect on the human wound, the PVB–Cur films with UV-blocking properties may be advantageous for inhibiting DNA rupture and dimerization of thymine molecules presented in the human wound. The transparency of the PVB–Cur film (2.94) and the PVB film (2.95) was almost equivalent at 600 nm, which indicated the good compatibility between Cur and PVB film matrix. Cur-loaded PVB films also had corresponding visualizations in Figure 3b and c.

Light transmittance characteristics of PVB and PVB–Cur films. (a) PVB film under visible light and (b) PVB–Cur film under visible light (c).
3.3 Thermal stability
The thermal stability of PVB and PVB–Cur films was evaluated by the TGA. The primary thermograms of the films are shown in Figure 4 and the thermal properties are listed in Table 1. From the thermogram, it could be found that the residues of Cur powder and PVB–Cur film at 600°C were 40% and 1%, respectively, and the pure PVB film was completely degraded. The residue of Cur should be attributed to the presence of the phenyl rings. The initial weight loss temperatures (Tonset) of Cur powder, PVB film, and PVB–Cur film were 255°C, 290°C, and 310°C, respectively. Their maximum decomposition rates (Tmax) were recorded at 370°C, 376°C, and 396°C, respectively. The T10% (T10% is the temperature of degradation at 10 wt% loss) values of PVB film and PVB–Cur film were 327°C and 344°C, respectively. The PVB–Cur film showed higher T10%, and Tonset and Tmax values relative to the neat PVB film. This indicated that the degradation was shifted to a higher temperature, and the thermal stability of the composite film was improved by adding Cur to the PVB polymer matrix. The improved thermal stability observed for the PVB–Cur films might be attributed to the good dispersion of Cur in the polymer matrix. Meanwhile, these results indicated the potential of the PVB–Cur films applied at high temperatures.

Thermal stability of PVB, Cur, and PVB–Cur films.
Thermal stability parameters for the PVB and PVB–Cur films.
| Sample | Tonset (°C) | T10% (°C) | Tmax (°C) | Residue (%) |
|---|---|---|---|---|
| Cur | 255 | 297 | 370 | 40 |
| PVB | 290 | 327 | 376 | 0 |
| PVB–Cur | 310 | 344 | 396 | 1 |
3.4 Mechanical property
Figure 5 shows the tensile stress–strain curves of the PVB and PVB–Cur films. The tensile strength of pure PVB film and PVB–Cur film was 6 and 7.5 MPa, and the elongation at break was 207% and 222%, respectively. The results demonstrated that the incorporation of Cur did not impair the mechanical properties of the films. The good mechanical properties of PVB–Cur composite films could be explained by a good interfacial interaction between Cur and PVB (20). It can be observed in Figure 5 that both PVB and PVB–Cur films exhibited yield behavior during tensile testing. This indicated that the film was not brittle, but an elastic plastic material. The stress–strain curves of PVB–Cur films exhibited elastic deformation regions with high modulus at the initial stage. The yield points were observed at approximately 3.5% strain. Subsequently, the strain-hardening region appeared in the stress–strain curve. At this stage, the enhancement in stress was accompanied by further elongation of the film. The excellent mechanical properties made the resulting films suitable candidates for food packaging (36).

Strain–stress curves of PVB and PVB–Cur composite films.
3.5 Wettability property
The wettability of the film surfaces was investigated by measuring the water contact angle. Generally, when the angle between the water droplet and the surface of the film is less than 90° the surface of the film is judged to be hydrophilic, whereas the surface exceeding 90° is hydrophobic. Figure 6 shows the contact angle of the PVB film with and without Cur. Contact angle values at different times (0, 30, 60, 90, 120 s, respectively) were measured to analyze the time dependence. The starting contact angle of the PVB–Cur film was slightly lower than that of the PVB film. The starting contact angles of the PVB film and the PVB–Cur film were 78.1 ± 0.5° and 75.8 ± 0.6°, respectively. Therefore, both the PVB film and the PVB–Cur film were hydrophilic. Typically, the surface of the wound dressing with water contact angle of 60° to 80° could facilitate the adhesion and proliferation of cells at the wound (37). In addition, the contact angles of the PVB film and the PVB–Cur film were not constant, and there was a slight decrease of about 3° during the contact time of 0–60 s. After 60 s, the contact angle basically reached equilibrium. The incorporation of Cur slightly enhanced the hydrophilicity of the film, and the contact angle of the composite film could be maintained within the range that was favorable for wound healing.

(a) Contact angle pictures and (b and c) contact angle values of water droplets on the surface of PVB and PVB–Cur films at different times.
3.6 Antibacterial activity
Bacterial proliferation is a key factor in causing food spoilage and wound infections. Therefore, the antibacterial property is very important for the application of film materials. Since S. aureus and E. coli are two common infectious species of bacteria in the natural environment, the activities of PVB–Cur film against these species were evaluated in vitro. The CFU quantification method was used to evaluate the antibacterial behavior of the materials. As shown in Figure 7, the PVB film did not exhibit noticeable antibacterial activity, compared to the Control group (p > 0.05). PVB–Cur film and Cur groups both possessed the ability to inhibit the growth of S. aureus and E. coli bacteria. The quantitative result of the colony count of S. aureus in the PVB–Cur film was 0.61 ± 0.17 × 108, which was not different from that of the Cur group (0.45 ± 0.09 × 108), but significantly lower than those of the Control group and the PVB film group (***p < 0.001, one-way ANOVA with statistical software SPSS 14.0 (SPSS Inc., Chicago, USA)). The quantitative result of the colony count of E. coli in the PVB–Cur film was 1.65 ± 0.22 × 108, which was also significantly lower than those of the Control group and the PVB film group (***p < 0.001). Therefore, the PVB–Cur film has robust antibacterial properties against both S. aureus and E. coli.
Antibacterial assays of S. aureus and E. coli. CFU photographs of S. aureus (a) and quantitative results (c). CFU photographs of E. coli. (b) and quantitative results (d).
So far, the antibacterial mechanism of Cur has not been fully understood. Some studies had shown that the antibacterial effect of Cur was related to FtsZ, which was a cytoskeletal protein that plays an important role in the process of prokaryotic cell division. Here, Cur inhibited the growth of E. coli mainly by inhibiting the assembled FtsZ. In addition, Cur could damage bacterial membranes and improve their permeability. Cur is believed to have antibacterial properties by anchoring the cell wall of the bacterial cell, causing it to rupture and then infiltrating into the cell, destroying the structure of the organelle (38,39,40).
4 Conclusion
In this paper, PVB–Cur composite film was prepared using ethanol as the film-forming dispersions. FTIR spectroscopy analysis suggested that there were interactions between Cur and the PVB matrix. The UV-visible analysis indicated that the composite films exhibited better ultraviolet radiation-blocking properties than PVB films. Moreover, the addition of Cur improved the mechanical properties, hydrophilicity, and thermal properties of the PVB–Cur composite films. More importantly, the incorporation of Cur into the PVB matrix endowed the composite film with excellent antibacterial properties toward E. coli. Hence, the PVB–Cur composite film could be considered as potential candidate in the medical and food packaging industries.
Acknowledgment
This research was supported by a grant from the National Natural Science Foundation of China (NSFC) (No. 51703012).
References
(1) Liu C, Faria AF, Ma J, Elimelech M. Mitigation of biofilm development on thin-film composite membranes functionalized with zwitterionic polymers and silver nanoparticles. Environ Sci Technol. 2017;51:182–91.10.1021/acs.est.6b03795Search in Google Scholar PubMed
(2) Yalcinkaya F, Lubasova D. Quantitative evaluation of antibacterial activities of nanoparticles (ZnO, TiO2, ZnO/TiO2, SnO2, CuO, ZrO2, and AgNO3) incorporated into polyvinyl butyral nanofibers: quantitative evaluation of antibacterial activities of nanoparticles. Polym Adv Technol. 2017;28:137–40.10.1002/pat.3883Search in Google Scholar
(3) Wei Q, Wang X, Cheng J-H, Zeng G, Sun D-W. Synthesis and antimicrobial activities of novel sorbic and benzoic acid amide derivatives. Food Chem. 2018;268:220–32.10.1016/j.foodchem.2018.06.071Search in Google Scholar PubMed
(4) Yemenicioğlu A. Zein and its composites and blends with natural active compounds. Antimicrobial food packaging. Dordrecht, Netherlands: Elsevier; 2016. p. 503–13. ISBN 978-0-12-800723-5.10.1016/B978-0-12-800723-5.00041-3Search in Google Scholar
(5) Liu X, You L, Tarafder S, Zou L, Fang Z, Chen J, et al. Curcumin-releasing chitosan/aloe membrane for skin regeneration. Chem Eng J. 2019;359:1111–9.10.1016/j.cej.2018.11.073Search in Google Scholar
(6) Cetin-Karaca H, Newman MC. Antimicrobial efficacy of plant phenolic compounds against Salmonella and Escherichia Coli. Food Biosci. 2015;11:8–16.10.1016/j.fbio.2015.03.002Search in Google Scholar
(7) Liu J, Liu S, Wu Q, Gu Y, Kan J, Jin C. Effect of protocatechuic acid incorporation on the physical, mechanical, structural and antioxidant properties of chitosan film. Food Hydrocoll. 2017;73:90–100.10.1016/j.foodhyd.2017.06.035Search in Google Scholar
(8) Bastarrachea L, Dhawan S, Sablani SS. Engineering properties of polymeric-based antimicrobial films for food packaging: a review. Food Eng Rev. 2011;3:79–93.10.1007/s12393-011-9034-8Search in Google Scholar
(9) Huang K-S, Yang C-H, Huang S-L, Chen C-Y, Lu Y-Y, Lin Y-S. Recent advances in antimicrobial polymers: a mini-review. Int J Mol Sci. 2016;17:1578.10.3390/ijms17091578Search in Google Scholar PubMed PubMed Central
(10) Wu C-S. Enhanced antibacterial activity, antioxidant, and in vitro biocompatibility of modified polycaprolactone-based membranes. Int J Polym Mater Polym Biomater. 2016;65:872–80.10.1080/00914037.2016.1180605Search in Google Scholar
(11) Mogoşanu GD, Grumezescu AM. Natural and synthetic polymers for wounds and burns dressing. Int J Pharm. 2014;463:127–36.10.1016/j.ijpharm.2013.12.015Search in Google Scholar PubMed
(12) Wang L, Xue J, Zhang Y. Preparation and characterization of curcumin loaded caseinate/zein nanocomposite film using pH-driven method. Ind Crops Prod. 2019;130:71–80.10.1016/j.indcrop.2018.12.072Search in Google Scholar
(13) Ma Q, Cao L, Liang T, Li J, Lucia LA, Wang L. Active tara gum/PVA blend films with curcumin-loaded CTAC brush-TEMPO-oxidized cellulose nanocrystals. ACS Sustain Chem Eng. 2018;6:8926–34.10.1021/acssuschemeng.8b01281Search in Google Scholar
(14) Ma Q, Ren Y, Wang L. Investigation of antioxidant activity and release kinetics of curcumin from tara gum/polyvinyl alcohol active film. Food Hydrocoll. 2017;70:286–92.10.1016/j.foodhyd.2017.04.018Search in Google Scholar
(15) Akbik D, Ghadiri M, Chrzanowski W, Rohanizadeh R. Curcumin as a wound healing agent. Life Sci. 2014;116:1–7.10.1016/j.lfs.2014.08.016Search in Google Scholar PubMed
(16) Hussain Z, Thu HE, Amjad MW, Hussain F, Ahmed TA, Khan S. Exploring recent developments to improve antioxidant, anti-inflammatory and antimicrobial efficacy of curcumin: a review of new trends and future perspectives. Mater Sci Eng C. 2017;77:1316–26.10.1016/j.msec.2017.03.226Search in Google Scholar PubMed
(17) Mohanty C, Sahoo SK. Curcumin and its topical formulations for wound healing applications. Drug Discovery Today. 2017;22:1582–92.10.1016/j.drudis.2017.07.001Search in Google Scholar PubMed
(18) Anand P, Kunnumakkara AB, Newman RA, Aggarwal BB. Bioavailability of curcumin: problems and promises. Mol Pharm. 2007;4:807–18.10.1021/mp700113rSearch in Google Scholar PubMed
(19) Liu Y, Cai Y, Jiang X, Wu J, Le X. Molecular interactions, characterization and antimicrobial activity of curcumin–chitosan blend films. Food Hydrocoll. 2016;52:564–72.10.1016/j.foodhyd.2015.08.005Search in Google Scholar
(20) Luo N, Varaprasad K, Reddy GVS, Rajulu AV, Zhang J. Preparation and characterization of cellulose/curcumin composite films. RSC Adv. 2012;2:8483.10.1039/c2ra21465bSearch in Google Scholar
(21) Govindaraj P, Kandasubramanian B, Kodam KM. Molecular interactions and antimicrobial activity of curcumin (Curcuma longa) loaded polyacrylonitrile films. Mater Chem Phys. 2014;147:934–41.10.1016/j.matchemphys.2014.06.040Search in Google Scholar
(22) Li X, Nan K, Li L, Zhang Z, Chen H. In vivo evaluation of curcumin nanoformulation loaded methoxy poly(ethylene glycol)-graft-chitosan composite film for wound healing application. Carbohydr Polym. 2012;88:84–90.10.1016/j.carbpol.2011.11.068Search in Google Scholar
(23) Posavec D, Dorsch A, Bogner U, Bernhardt G, Nagl S. Polyvinyl butyral nanobeads: preparation, characterization, biocompatibility and cancer cell uptake. Microchim Acta. 2011;173:391–9.10.1007/s00604-011-0573-8Search in Google Scholar
(24) Liu G-S, Yan X, Yan F-F, Chen F-X, Hao L-Y, Chen S-J, et al. In situ electrospinning iodine-based fibrous meshes for antibacterial wound dressing. Nanoscale Res Lett. 2018;13:309.10.1186/s11671-018-2733-9Search in Google Scholar PubMed PubMed Central
(25) Chui C-Y, Mouthuy P-A, Ye H. Direct electrospinning of poly(vinyl butyral) onto human dermal fibroblasts using a portable device. Biotechnol Lett. 2018;40:737–44.10.1007/s10529-018-2522-7Search in Google Scholar PubMed PubMed Central
(26) Liu J, Wang H, Wang P, Guo M, Jiang S, Li X, et al. Films based on κ-carrageenan incorporated with curcumin for freshness monitoring. Food Hydrocoll. 2018;83:134–42.10.1016/j.foodhyd.2018.05.012Search in Google Scholar
(27) Wong S, Zhao J, Cao C, Wong CK, Kuchel RP, De Luca S, et al. Just add sugar for carbohydrate induced self-assembly of curcumin. Nat Commun. 2019;10:582.10.1038/s41467-019-08402-ySearch in Google Scholar PubMed PubMed Central
(28) Pan J, Cao D, Ma X, Yang J. Preparation, characterization and in vitro release properties of pectin-based curcumin film. Korean J Chem Eng. 2019;36:822–7.10.1007/s11814-019-0238-6Search in Google Scholar
(29) Coscia MG, Bhardwaj J, Singh N, Santonicola MG, Richardson R, Thakur VK, et al. Manufacturing & characterization of regenerated cellulose/curcumin based sustainable composites fibers spun from environmentally benign solvents. Ind Crops Prod. 2018;111:536–43.10.1016/j.indcrop.2017.09.041Search in Google Scholar
(30) Chen S, Chen X, Wu X. The mechanical behaviour of polyvinyl butyral at intermediate strain rates and different temperatures. Constr Build Mater. 2018;182:66–79.10.1016/j.conbuildmat.2018.06.080Search in Google Scholar
(31) Xu S-C, Qin C-C, Yu M, Dong R-H, Yan X, Zhao H, et al. A battery-operated portable handheld electrospinning apparatus. Nanoscale. 2015;7:12351–5.10.1039/C5NR02922HSearch in Google Scholar
(32) Musso YS, Salgado PR, Mauri AN. Smart edible films based on gelatin and curcumin. Food Hydrocoll. 2017;66:8–15.10.1016/j.foodhyd.2016.11.007Search in Google Scholar
(33) Wang H, Hao L, Wang P, Chen M, Jiang S, Jiang S. Release kinetics and antibacterial activity of curcumin loaded zein fibers. Food Hydrocoll. 2017;63:437–46.10.1016/j.foodhyd.2016.09.028Search in Google Scholar
(34) Mohammadian-Kohol M, Nasrabadi MN, Navarchian AH, Jabbari I, Seyedhabashi MR. A study of the effects of gamma irradiation on the structural and mechanical properties of polyvinyl butyral film. Radiat Phys Chem. 2018;152:1–5.10.1016/j.radphyschem.2018.07.014Search in Google Scholar
(35) Ma Q, Du L, Wang L. Tara gum/polyvinyl alcohol-based colorimetric NH3 indicator films incorporating curcumin for intelligent packaging. Sens Actuators B. 2017;244:759–66.10.1016/j.snb.2017.01.035Search in Google Scholar
(36) Haraguchi K, Ebato M, Takehisa T. Polymer–clay nanocomposites exhibiting abnormal necking phenomena accompanied by extremely large reversible elongations and excellent transparency. Adv Mater. 2006;18:2250–4.10.1002/adma.200600143Search in Google Scholar
(37) Mu X, Yu H, Zhang C, Chen X, Cheng Z, Bai R, et al. Nano-porous nitrocellulose liquid bandage modulates cell and cytokine response and accelerates cutaneous wound healing in a mouse model. Carbohydr Polym. 2016;136:618–29.10.1016/j.carbpol.2015.08.070Search in Google Scholar PubMed
(38) Kaur S, Modi NH, Panda D, Roy N. Probing the binding site of curcumin in Escherichia coli and Bacillus subtilis FtsZ – A structural insight to unveil antibacterial activity of curcumin. Eur J Med Chem. 2010;45:4209–14.10.1016/j.ejmech.2010.06.015Search in Google Scholar PubMed
(39) Tyagi P, Singh M, Kumari H, Kumari A, Mukhopadhyay K. Bactericidal activity of curcumin I is associated with damaging of bacterial membrane. PLoS One. 2015;10:1–15.10.1371/journal.pone.0121313Search in Google Scholar PubMed PubMed Central
(40) Bhawana Basniwal RK, Buttar HS, Jain VK, Jain N. Curcumin nanoparticles: preparation, characterization, and antimicrobial study. J Agric Food Chem. 2011;59:2056–61.10.1021/jf104402tSearch in Google Scholar PubMed
© 2020 Yanchao Qiao and Lijie Duan, published by De Gruyter
This work is licensed under the Creative Commons Attribution 4.0 International License.
Articles in the same Issue
- Regular Articles
- The regulatory effects of the number of VP(N-vinylpyrrolidone) function groups on macrostructure and photochromic properties of polyoxometalates/copolymer hybrid films
- How the hindered amines affect the microstructure and mechanical properties of nitrile-butadiene rubber composites
- Novel benzimidazole-based conjugated polyelectrolytes: synthesis, solution photophysics and fluorescent sensing of metal ions
- Study on the variation of rock pore structure after polymer gel flooding
- Investigation on compatibility of PLA/PBAT blends modified by epoxy-terminated branched polymers through chemical micro-crosslinking
- Investigation on degradation mechanism of polymer blockages in unconsolidated sandstone reservoirs
- Investigation on the effect of active-polymers with different functional groups for EOR
- Fabrication and characterization of hexadecyl acrylate cross-linked phase change microspheres
- Surface-induced phase transitions in thin films of dendrimer block copolymers
- ZnO-assisted coating of tetracalcium phosphate/ gelatin on the polyethylene terephthalate woven nets by atomic layer deposition
- Animal fat and glycerol bioconversion to polyhydroxyalkanoate by produced water bacteria
- Effect of microstructure on the properties of polystyrene microporous foaming material
- Synthesis of amphiphilic poly(ethylene glycol)-block-poly(methyl methacrylate) containing trityl ether acid cleavable junction group and its self-assembly into ordered nanoporous thin films
- On-demand optimize design of sound-absorbing porous material based on multi-population genetic algorithm
- Enhancement of mechanical, thermal and water uptake performance of TPU/jute fiber green composites via chemical treatments on fiber surface
- Enhancement of mechanical properties of natural rubber–clay nanocomposites through incorporation of silanated organoclay into natural rubber latex
- Preparation and characterization of corn starch/PVA/glycerol composite films incorporated with ε-polylysine as a novel antimicrobial packaging material
- Preparation of novel amphoteric polyacrylamide and its synergistic retention with cationic polymers
- Effect of montmorillonite on PEBAX® 1074-based mixed matrix membranes to be used in humidifiers in proton exchange membrane fuel cells
- Insight on the effect of a piperonylic acid derivative on the crystallization process, melting behavior, thermal stability, optical and mechanical properties of poly(l-lactic acid)
- Lipase-catalyzed synthesis and post-polymerization modification of new fully bio-based poly(hexamethylene γ-ketopimelate) and poly(hexamethylene γ-ketopimelate-co-hexamethylene adipate) copolyesters
- Dielectric, mechanical and thermal properties of all-organic PI/PSF composite films by in situ polymerization
- Morphological transition of amphiphilic block copolymer/PEGylated phospholipid complexes induced by the dynamic subtle balance interactions in the self-assembled aggregates
- Silica/polymer core–shell particles prepared via soap-free emulsion polymerization
- Antibacterial epoxy composites with addition of natural Artemisia annua waste
- Design and preparation of 3D printing intelligent poly N,N-dimethylacrylamide hydrogel actuators
- Multilayer-structured fibrous membrane with directional moisture transportability and thermal radiation for high-performance air filtration
- Reaction characteristics of polymer expansive jet impact on explosive reactive armour
- Synthesis of a novel modified chitosan as an intumescent flame retardant for epoxy resin
- Synthesis of aminated polystyrene and its self-assembly with nanoparticles at oil/water interface
- The synthesis and characterisation of porous and monodisperse, chemically modified hypercrosslinked poly(acrylonitrile)-based terpolymer as a sorbent for the adsorption of acidic pharmaceuticals
- Crystal transition and thermal behavior of Nylon 12
- All-optical non-conjugated multi-functionalized photorefractive polymers via ring-opening metathesis polymerization
- Fabrication of LDPE/PS interpolymer resin particles through a swelling suspension polymerization approach
- Determination of the carbonyl index of polyethylene and polypropylene using specified area under band methodology with ATR-FTIR spectroscopy
- Synthesis, electropolymerization, and electrochromic performances of two novel tetrathiafulvalene–thiophene assemblies
- Wetting behaviors of fluoroterpolymer fiber films
- Plugging mechanisms of polymer gel used for hydraulic fracture water shutoff
- Synthesis of flexible poly(l-lactide)-b-polyethylene glycol-b-poly(l-lactide) bioplastics by ring-opening polymerization in the presence of chain extender
- Sulfonated poly(arylene ether sulfone) functionalized polysilsesquioxane hybrid membranes with enhanced proton conductivity
- Fmoc-diphenylalanine-based hydrogels as a potential carrier for drug delivery
- Effect of diacylhydrazine as chain extender on microphase separation and performance of energetic polyurethane elastomer
- Improved high-temperature damping performance of nitrile-butadiene rubber/phenolic resin composites by introducing different hindered amine molecules
- Rational synthesis of silicon into polyimide-derived hollow electrospun carbon nanofibers for enhanced lithium storage
- Synthesis, characterization and properties of phthalonitrile-etherified resole resin
- Highly thermally conductive boron nitride@UHMWPE composites with segregated structure
- Synthesis of high-temperature thermally expandable microcapsules and their effects on foaming quality and surface quality of foamed ABS materials
- Tribological and nanomechanical properties of a lignin-based biopolymer
- Hydroxyapatite/polyetheretherketone nanocomposites for selective laser sintering: Thermal and mechanical performances
- Synthesis of a phosphoramidate flame retardant and its flame retardancy on cotton fabrics
- Preparation and characterization of thermoresponsive poly(N-isopropylacrylamide) copolymers with enhanced hydrophilicity
- Fabrication of flexible SiO2 nanofibrous yarn via a conjugate electrospinning process
- Silver-loaded carbon nanofibers for ammonia sensing
- Polar migration behavior of phosphonate groups in phosphonate esterified acrylic grafted epoxy ester composites and their role in substrate protection
- Solubility and diffusion coefficient of supercritical CO2 in polystyrene dynamic melt
- Curcumin-loaded polyvinyl butyral film with antibacterial activity
- Experimental-numerical studies of the effect of cell structure on the mechanical properties of polypropylene foams
- Experimental investigation on the three-dimensional flow field from a meltblowing slot die
- Enhancing tribo-mechanical properties and thermal stability of nylon 6 by hexagonal boron nitride fillers
- Preparation and characterization of electrospun fibrous scaffolds of either PVA or PVP for fast release of sildenafil citrate
- Seawater degradation of PLA accelerated by water-soluble PVA
- Review Article
- Mechanical properties and application analysis of spider silk bionic material
- Additive manufacturing of PLA-based scaffolds intended for bone regeneration and strategies to improve their biological properties
- Structural design toward functional materials by electrospinning: A review
- Special Issue: XXXII National Congress of the Mexican Polymer Society
- Tailoring the morphology of poly(high internal phase emulsions) synthesized by using deep eutectic solvents
- Modification of Ceiba pentandra cellulose for drug release applications
- Redox initiation in semicontinuous polymerization to search for specific mechanical properties of copolymers
- pH-responsive polymer micelles for methotrexate delivery at tumor microenvironments
- Microwave-assisted synthesis of the lipase-catalyzed ring-opening copolymerization of ε-caprolactone and ω-pentadecanolactone: Thermal and FTIR characterization
- Rapid Communications
- Pilot-scale production of polylactic acid nanofibers by melt electrospinning
- Erratum
- Erratum to: Synthesis and characterization of new macromolecule systems for colon-specific drug delivery
Articles in the same Issue
- Regular Articles
- The regulatory effects of the number of VP(N-vinylpyrrolidone) function groups on macrostructure and photochromic properties of polyoxometalates/copolymer hybrid films
- How the hindered amines affect the microstructure and mechanical properties of nitrile-butadiene rubber composites
- Novel benzimidazole-based conjugated polyelectrolytes: synthesis, solution photophysics and fluorescent sensing of metal ions
- Study on the variation of rock pore structure after polymer gel flooding
- Investigation on compatibility of PLA/PBAT blends modified by epoxy-terminated branched polymers through chemical micro-crosslinking
- Investigation on degradation mechanism of polymer blockages in unconsolidated sandstone reservoirs
- Investigation on the effect of active-polymers with different functional groups for EOR
- Fabrication and characterization of hexadecyl acrylate cross-linked phase change microspheres
- Surface-induced phase transitions in thin films of dendrimer block copolymers
- ZnO-assisted coating of tetracalcium phosphate/ gelatin on the polyethylene terephthalate woven nets by atomic layer deposition
- Animal fat and glycerol bioconversion to polyhydroxyalkanoate by produced water bacteria
- Effect of microstructure on the properties of polystyrene microporous foaming material
- Synthesis of amphiphilic poly(ethylene glycol)-block-poly(methyl methacrylate) containing trityl ether acid cleavable junction group and its self-assembly into ordered nanoporous thin films
- On-demand optimize design of sound-absorbing porous material based on multi-population genetic algorithm
- Enhancement of mechanical, thermal and water uptake performance of TPU/jute fiber green composites via chemical treatments on fiber surface
- Enhancement of mechanical properties of natural rubber–clay nanocomposites through incorporation of silanated organoclay into natural rubber latex
- Preparation and characterization of corn starch/PVA/glycerol composite films incorporated with ε-polylysine as a novel antimicrobial packaging material
- Preparation of novel amphoteric polyacrylamide and its synergistic retention with cationic polymers
- Effect of montmorillonite on PEBAX® 1074-based mixed matrix membranes to be used in humidifiers in proton exchange membrane fuel cells
- Insight on the effect of a piperonylic acid derivative on the crystallization process, melting behavior, thermal stability, optical and mechanical properties of poly(l-lactic acid)
- Lipase-catalyzed synthesis and post-polymerization modification of new fully bio-based poly(hexamethylene γ-ketopimelate) and poly(hexamethylene γ-ketopimelate-co-hexamethylene adipate) copolyesters
- Dielectric, mechanical and thermal properties of all-organic PI/PSF composite films by in situ polymerization
- Morphological transition of amphiphilic block copolymer/PEGylated phospholipid complexes induced by the dynamic subtle balance interactions in the self-assembled aggregates
- Silica/polymer core–shell particles prepared via soap-free emulsion polymerization
- Antibacterial epoxy composites with addition of natural Artemisia annua waste
- Design and preparation of 3D printing intelligent poly N,N-dimethylacrylamide hydrogel actuators
- Multilayer-structured fibrous membrane with directional moisture transportability and thermal radiation for high-performance air filtration
- Reaction characteristics of polymer expansive jet impact on explosive reactive armour
- Synthesis of a novel modified chitosan as an intumescent flame retardant for epoxy resin
- Synthesis of aminated polystyrene and its self-assembly with nanoparticles at oil/water interface
- The synthesis and characterisation of porous and monodisperse, chemically modified hypercrosslinked poly(acrylonitrile)-based terpolymer as a sorbent for the adsorption of acidic pharmaceuticals
- Crystal transition and thermal behavior of Nylon 12
- All-optical non-conjugated multi-functionalized photorefractive polymers via ring-opening metathesis polymerization
- Fabrication of LDPE/PS interpolymer resin particles through a swelling suspension polymerization approach
- Determination of the carbonyl index of polyethylene and polypropylene using specified area under band methodology with ATR-FTIR spectroscopy
- Synthesis, electropolymerization, and electrochromic performances of two novel tetrathiafulvalene–thiophene assemblies
- Wetting behaviors of fluoroterpolymer fiber films
- Plugging mechanisms of polymer gel used for hydraulic fracture water shutoff
- Synthesis of flexible poly(l-lactide)-b-polyethylene glycol-b-poly(l-lactide) bioplastics by ring-opening polymerization in the presence of chain extender
- Sulfonated poly(arylene ether sulfone) functionalized polysilsesquioxane hybrid membranes with enhanced proton conductivity
- Fmoc-diphenylalanine-based hydrogels as a potential carrier for drug delivery
- Effect of diacylhydrazine as chain extender on microphase separation and performance of energetic polyurethane elastomer
- Improved high-temperature damping performance of nitrile-butadiene rubber/phenolic resin composites by introducing different hindered amine molecules
- Rational synthesis of silicon into polyimide-derived hollow electrospun carbon nanofibers for enhanced lithium storage
- Synthesis, characterization and properties of phthalonitrile-etherified resole resin
- Highly thermally conductive boron nitride@UHMWPE composites with segregated structure
- Synthesis of high-temperature thermally expandable microcapsules and their effects on foaming quality and surface quality of foamed ABS materials
- Tribological and nanomechanical properties of a lignin-based biopolymer
- Hydroxyapatite/polyetheretherketone nanocomposites for selective laser sintering: Thermal and mechanical performances
- Synthesis of a phosphoramidate flame retardant and its flame retardancy on cotton fabrics
- Preparation and characterization of thermoresponsive poly(N-isopropylacrylamide) copolymers with enhanced hydrophilicity
- Fabrication of flexible SiO2 nanofibrous yarn via a conjugate electrospinning process
- Silver-loaded carbon nanofibers for ammonia sensing
- Polar migration behavior of phosphonate groups in phosphonate esterified acrylic grafted epoxy ester composites and their role in substrate protection
- Solubility and diffusion coefficient of supercritical CO2 in polystyrene dynamic melt
- Curcumin-loaded polyvinyl butyral film with antibacterial activity
- Experimental-numerical studies of the effect of cell structure on the mechanical properties of polypropylene foams
- Experimental investigation on the three-dimensional flow field from a meltblowing slot die
- Enhancing tribo-mechanical properties and thermal stability of nylon 6 by hexagonal boron nitride fillers
- Preparation and characterization of electrospun fibrous scaffolds of either PVA or PVP for fast release of sildenafil citrate
- Seawater degradation of PLA accelerated by water-soluble PVA
- Review Article
- Mechanical properties and application analysis of spider silk bionic material
- Additive manufacturing of PLA-based scaffolds intended for bone regeneration and strategies to improve their biological properties
- Structural design toward functional materials by electrospinning: A review
- Special Issue: XXXII National Congress of the Mexican Polymer Society
- Tailoring the morphology of poly(high internal phase emulsions) synthesized by using deep eutectic solvents
- Modification of Ceiba pentandra cellulose for drug release applications
- Redox initiation in semicontinuous polymerization to search for specific mechanical properties of copolymers
- pH-responsive polymer micelles for methotrexate delivery at tumor microenvironments
- Microwave-assisted synthesis of the lipase-catalyzed ring-opening copolymerization of ε-caprolactone and ω-pentadecanolactone: Thermal and FTIR characterization
- Rapid Communications
- Pilot-scale production of polylactic acid nanofibers by melt electrospinning
- Erratum
- Erratum to: Synthesis and characterization of new macromolecule systems for colon-specific drug delivery